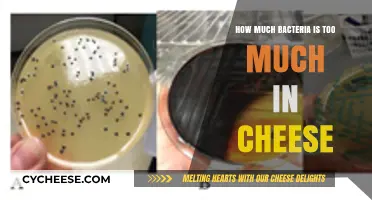
Understanding Safe Bacteria Levels in Cheese: When Is It Too Much?

The McDonald's Triple Cheeseburger is a popular menu item known for its hearty combination of three beef patties and melted cheese. A common question among consumers is how much beef is actually in this burger. Typically, each patty in a McDonald's Triple Cheeseburger weighs approximately 1.6 ounces (45 grams), meaning the total beef content in the burger is around 4.8 ounces (135 grams). This makes it a substantial option for those craving a meaty meal, though it’s important to consider the overall nutritional content, including calories and fat, when enjoying this indulgent treat.
Explore related products
What You'll Learn

Beef Content in Triple Cheeseburger
The McDonald's Triple Cheeseburger is a popular menu item known for its stacked layers of beef and cheese. Understanding the beef content in this burger is essential for consumers who are mindful of their protein intake or dietary preferences. According to McDonald's official nutritional information, the Triple Cheeseburger contains three 100% pure beef patties. Each patty weighs approximately 1.6 ounces (45 grams), making the total beef content in the burger around 4.8 ounces (135 grams). This information is crucial for those tracking their macronutrient intake, as beef is the primary source of protein in this meal.
The beef used in McDonald's Triple Cheeseburger is sourced from approved suppliers and is made from whole cuts of beef, with no additives or preservatives. The patties are seasoned with a simple blend of salt and pepper, ensuring the natural flavor of the beef shines through. It's important to note that while the beef content is substantial, the overall weight of the burger also includes buns, cheese, and condiments. For those specifically interested in the beef portion, the 4.8 ounces of beef provides a significant amount of protein, typically around 24 grams per burger, depending on the exact fat content of the beef.
When comparing the beef content in the Triple Cheeseburger to other McDonald's offerings, it’s clear that this burger is one of the more beef-heavy options. For instance, a regular Cheeseburger contains only one 1.6-ounce patty, while the Double Cheeseburger has two. The Triple Cheeseburger, therefore, offers a higher beef-to-bun ratio, making it a more protein-dense choice. This is particularly appealing to customers who prioritize meat in their meals or are looking for a more filling option.
For health-conscious consumers, understanding the beef content is also important for managing calorie and fat intake. The 4.8 ounces of beef in the Triple Cheeseburger contribute to a significant portion of the burger's total calories, which typically range between 450 to 520 calories, depending on the region and specific ingredients used. The fat content from the beef varies based on the lean-to-fat ratio of the meat, but it generally falls between 20 to 30 grams. This information allows customers to make informed decisions about their meal choices, especially if they are monitoring their fat or calorie consumption.
Lastly, for those with dietary restrictions or preferences, knowing the exact beef content in the Triple Cheeseburger can help in planning meals. Since the beef is 100% pure and free from additives, it is suitable for various diets, including keto or paleo. However, individuals with specific allergies or sensitivities should always check with McDonald's for the most up-to-date ingredient information. By focusing on the beef content, customers can better tailor their McDonald's experience to meet their nutritional needs and preferences.
Exploring the Price of a Wheel of Swiss Cheese: Costs Revealed
You may want to see also

Calories from Beef in Triple Cheese
The McDonald's Triple Cheeseburger is a popular menu item known for its hearty portion of beef and cheese. To understand the calories from beef in this burger, it's essential to break down its components. The Triple Cheeseburger consists of three 100% beef patties, each weighing approximately 1.6 ounces (45 grams). According to McDonald's nutritional information, a single patty contains around 150 calories. Therefore, the total calories from beef in the Triple Cheeseburger can be calculated by multiplying the calories per patty by the number of patties: 150 calories/patty * 3 patties = 450 calories from beef.
When considering the overall calorie content of the Triple Cheeseburger, the beef patties contribute significantly. The entire burger contains approximately 540 calories, with the beef accounting for over 83% of the total calorie count. This highlights the substantial role that beef plays in the nutritional profile of this menu item. For individuals monitoring their calorie intake, understanding the breakdown of calories from beef is crucial, as it allows for better decision-making when choosing fast-food options.
It's worth noting that the calorie content of beef in the Triple Cheeseburger can vary slightly depending on factors such as cooking method and regional differences. However, McDonald's standardized recipes and cooking procedures ensure consistency across most locations. The beef used in their patties is sourced from reputable suppliers and is free from additives, ensuring that the calorie count remains accurate and reliable. This transparency in nutritional information empowers customers to make informed choices about their meals.
For those looking to reduce their calorie intake while still enjoying a Triple Cheeseburger, one option is to customize the order. Removing one or more patties will directly decrease the calories from beef, allowing for a more tailored meal. Additionally, opting for lighter toppings or skipping the cheese can further reduce the overall calorie count. By focusing on the beef component, customers can better manage their dietary goals without entirely sacrificing their favorite menu items.
In summary, the calories from beef in McDonald's Triple Cheeseburger amount to approximately 450 calories, derived from three 1.6-ounce patties. This significant portion of the burger's total calorie content underscores the importance of beef in its nutritional profile. Understanding this breakdown enables customers to make informed choices, whether they aim to enjoy the burger as is or customize it to align with their dietary preferences. As always, moderation and awareness are key when incorporating fast-food options into a balanced diet.
Exploring the Availability of Cold Pack Cheese Across the United States
You may want to see also

Beef Source for McDonald’s Triple Cheese
McDonald's Triple Cheese Burger is a popular menu item known for its three beef patties, making the source and quality of beef a critical aspect of its appeal. The beef used in McDonald's Triple Cheese Burger is sourced from approved suppliers who adhere to strict standards set by the company. These suppliers are primarily located in regions where McDonald's operates, ensuring a consistent and reliable supply chain. For instance, in the United States, McDonald's works with local farmers and ranchers who follow the company's guidelines for raising cattle. This includes practices that prioritize animal welfare, sustainability, and food safety, ensuring that the beef meets both regulatory requirements and McDonald's own quality benchmarks.
The beef patties in the Triple Cheese Burger are made from 100% pure beef with no additives, fillers, or preservatives. McDonald's emphasizes transparency in its sourcing practices, stating that the beef comes from whole cuts of the chuck, round, and sirloin, which are then ground and formed into patties. This commitment to using only pure beef is a key differentiator for the brand, as it ensures that customers receive a product free from artificial ingredients. The company also conducts regular audits and inspections of its suppliers to maintain these standards, reinforcing trust in the quality of the beef used in their burgers.
In terms of quantity, each Triple Cheese Burger contains three 1.6-ounce (45-gram) beef patties, totaling 4.8 ounces (135 grams) of beef per burger. This substantial amount of beef is a significant factor in the burger's popularity, as it provides a hearty and satisfying meal. McDonald's ensures that the beef is consistently portioned across all locations by using standardized patty sizes and cooking procedures. This uniformity is achieved through rigorous training of restaurant staff and the use of specialized equipment to cook the patties to the correct temperature and texture.
Sustainability is another important consideration in McDonald's beef sourcing for the Triple Cheese Burger. The company has committed to reducing its environmental footprint by working with suppliers who implement sustainable farming practices. This includes efforts to reduce greenhouse gas emissions, improve water efficiency, and promote responsible land use. McDonald's is also a member of the Global Roundtable for Sustainable Beef, which aims to advance sustainability in the global beef industry. These initiatives ensure that the beef used in the Triple Cheese Burger is not only of high quality but also produced in an environmentally responsible manner.
Finally, McDonald's places a strong emphasis on traceability and accountability in its beef supply chain. The company uses advanced tracking systems to monitor the journey of beef from farm to restaurant, ensuring that every patty in the Triple Cheese Burger can be traced back to its source. This level of transparency is crucial for maintaining consumer confidence and adhering to food safety regulations. By prioritizing traceability, McDonald's can quickly address any issues that may arise, further solidifying its reputation as a trusted provider of quality beef products. In summary, the beef source for McDonald's Triple Cheese Burger is characterized by its purity, consistency, sustainability, and traceability, all of which contribute to the burger's enduring popularity.
Daily Calcium Needs: How Much Cheese Should You Eat?
You may want to see also
Explore related products

Beef Quality in Triple Cheeseburger
The McDonald's Triple Cheeseburger is a popular menu item known for its simplicity and value, featuring three beef patties, cheese, pickles, onions, ketchup, and mustard. When it comes to beef quality in the Triple Cheeseburger, McDonald's emphasizes consistency and safety across its global supply chain. The beef used in their patties is sourced from approved suppliers who adhere to strict standards for animal welfare and sustainability. These suppliers are required to follow guidelines that ensure the cattle are raised in humane conditions and processed in facilities that meet high hygiene and quality benchmarks. This commitment to quality begins at the farm level, where cattle are fed a balanced diet to promote health and optimal meat quality.
The beef patties in the Triple Cheeseburger are made from 100% pure beef with no additives, fillers, or preservatives. McDonald's ensures that the beef is ground and formed into patties under rigorous quality control measures to maintain uniformity in taste and texture. Each patty is pre-cooked and then flash-frozen to lock in freshness before being distributed to restaurants. This process allows McDonald's to deliver a consistent product across all locations, ensuring that customers receive the same beef quality whether they're in New York or Tokyo. The simplicity of the ingredients highlights the importance of using high-quality beef, as it is the primary component of the burger.
One aspect of beef quality in the Triple Cheeseburger is the attention to food safety. McDonald's works closely with suppliers to implement Hazard Analysis and Critical Control Points (HACCP) systems, which identify and mitigate potential risks in the production process. This includes monitoring temperature controls, preventing cross-contamination, and conducting regular audits to ensure compliance with food safety regulations. By prioritizing safety, McDonald's ensures that the beef in their Triple Cheeseburger meets the highest standards for consumption.
Sustainability is another factor that influences beef quality in the Triple Cheeseburger. McDonald's has made significant strides in sourcing beef from suppliers who practice sustainable farming methods. This includes efforts to reduce greenhouse gas emissions, improve land management, and promote water conservation in beef production. By supporting sustainable practices, McDonald's not only enhances the quality of the beef but also contributes to the long-term health of the environment. These initiatives align with the growing consumer demand for ethically and sustainably produced food.
Finally, the beef quality in the Triple Cheeseburger is reflected in its taste and texture. The patties are seasoned with a simple blend of salt and pepper, allowing the natural flavor of the beef to shine. The cooking process, which involves grilling the patties on a flat-top grill, creates a slightly charred exterior while keeping the interior juicy. This combination of high-quality beef and precise cooking techniques ensures that the Triple Cheeseburger delivers a satisfying and consistent experience for customers. While it may not be premium or gourmet beef, the focus on purity, safety, and sustainability makes it a reliable choice for those seeking an affordable and flavorful burger.
Cheddar Cheese Fat Content: Uncovering the Truth About This Dairy Delight
You may want to see also

Beef-to-Bun Ratio in Triple Cheese
The beef-to-bun ratio is a critical factor in evaluating the satisfaction derived from any burger, and McDonald’s Triple Cheese is no exception. This burger features three beef patties layered with cheese, making the beef content a central focus. Understanding the beef-to-bun ratio helps consumers gauge whether the burger leans more toward a meat-heavy experience or a bun-dominated one. In the case of the Triple Cheese, the ratio is inherently skewed toward beef due to the presence of three patties, which significantly outweigh the single bun holding them together. This makes it a prime choice for those who prioritize meat in their burger experience.
McDonald’s Triple Cheese typically includes three 1.6-ounce (45-gram) beef patties, totaling 4.8 ounces (135 grams) of beef. The bun, while substantial, is designed to complement rather than overpower the beef. When calculating the beef-to-bun ratio, it’s essential to consider the weight and density of both components. The bun’s weight varies but generally falls between 2 to 3 ounces (57 to 85 grams). Using these figures, the beef-to-bun ratio in the Triple Cheese ranges from 1.6:1 to 2.4:1, depending on the bun’s exact weight. This ratio underscores the burger’s meat-forward profile, ensuring that beef remains the star of the show.
Achieving an optimal beef-to-bun ratio in the Triple Cheese requires careful assembly and ingredient proportioning. The three patties are stacked with cheese in between, ensuring that each bite delivers a substantial amount of beef. The bun’s role is to provide structure and balance without overwhelming the meat. McDonald’s ensures consistency by standardizing patty and bun sizes across their menu, allowing customers to expect a reliable beef-to-bun ratio every time they order a Triple Cheese. This consistency is a key factor in the burger’s popularity among beef enthusiasts.
For those who prefer an even higher beef-to-bun ratio, customization options are available. Customers can request additional patties or opt for a lighter bun, further tipping the scales in favor of beef. Conversely, those who enjoy a more balanced bite can add toppings like lettuce, tomatoes, or sauces, which slightly reduce the perceived beef dominance. However, the Triple Cheese’s default configuration already caters to meat lovers, with its generous beef content and carefully proportioned bun ensuring a satisfying ratio.
In conclusion, the beef-to-bun ratio in McDonald’s Triple Cheese is a standout feature, with three patties totaling 4.8 ounces of beef paired with a single bun weighing 2 to 3 ounces. This results in a ratio ranging from 1.6:1 to 2.4:1, emphasizing the burger’s meat-heavy nature. The thoughtful assembly and standardized ingredients ensure consistency, making the Triple Cheese a go-to option for those seeking a beef-forward burger experience. Whether enjoyed as-is or customized, the Triple Cheese’s beef-to-bun ratio remains a key factor in its appeal.
Folios Cheese Wraps Price Guide: Cost Breakdown and Budget Tips
You may want to see also
Frequently asked questions
A McDonald's Triple Cheeseburger contains approximately 8.4 ounces (238 grams) of beef, divided into three 10:1 (2.8 ounces or 80 grams each) beef patties.
A McDonald's Triple Cheeseburger contains around 540 calories.
The Triple Cheeseburger provides about 33 grams of protein, primarily from the beef patties.
The price of a McDonald's Triple Cheeseburger varies by location but typically ranges from $2.50 to $4.00.
A Triple Cheeseburger includes three slices of American cheese, totaling approximately 3 ounces (85 grams).